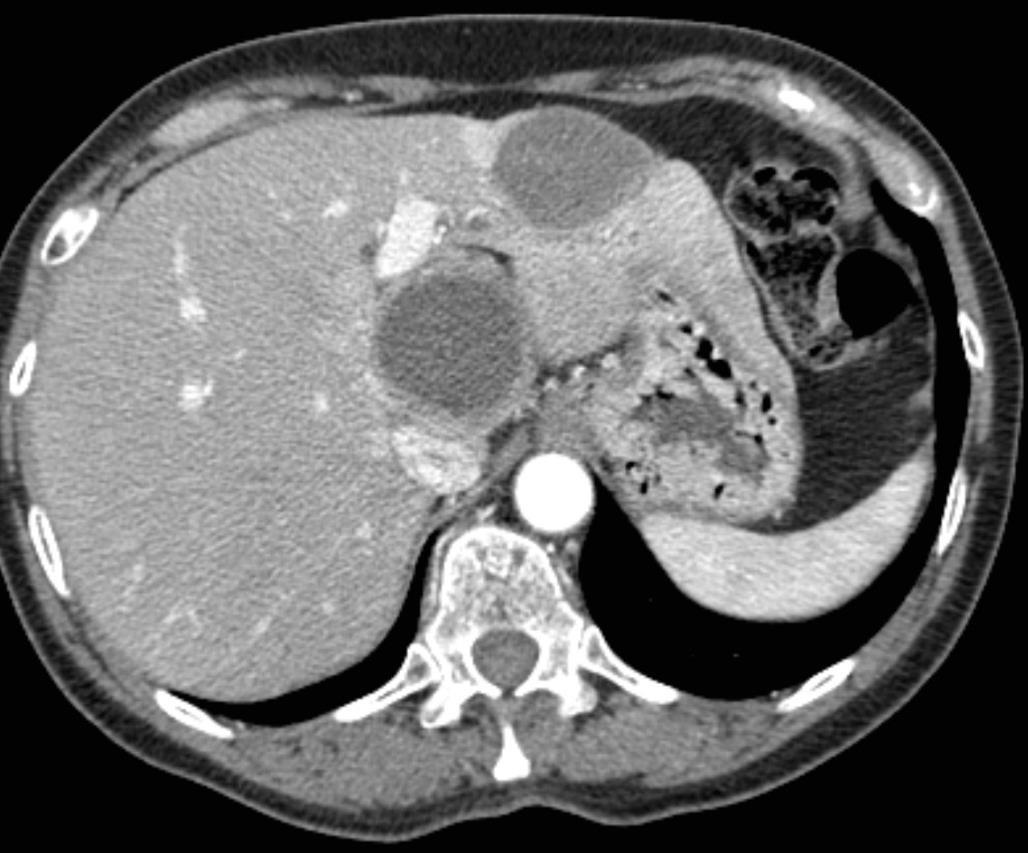

背景单纯肝动脉栓塞的背景 Bland embolisation: BackgroundTAE涉及供血动脉的靶向肿瘤的血管内闭塞。TAE在肝细胞癌治疗中的应用已超过30年【Marelli L, 2007】。这种形式的栓塞通常单独使用明胶海绵颗粒、球形栓塞剂或PVA颗粒完成,通常被称为“Bland”栓塞。虽然具体的技术和材料有很大的变化,但基本的目标是通过阻断肿瘤的血管供应来实现严重缺氧诱导细胞死亡。当前不同的栓塞技术应用于经肝动脉栓塞性化疗(transarterial chemoembolization TACE)
但我们回溯时会发现,而最初的肝动脉栓塞是TAE(bland embolization)。就有效性和安全性来说,单纯栓塞(TAE)并没有想象中的那么差。 肝癌单纯栓塞(Bland embolization)是基于肿瘤对缺氧的敏感性而不是细胞对化疗或放疗的敏感性。Bland embolisation is based on tumor sensitivity to anoxia rather than cells chemo or radio sensitivity. 肝癌细胞在培养基内的肝癌细胞,不同的缺氧时间细胞死亡的变化不一样,如果24小时缺氧,细胞100%的死亡。只是我们还不能让人体内的癌细胞这么长时间的缺氧。
TAE:患者的选择一般而言,TAE只用于有肝脏内肿瘤的不可手术患者。对于BCLC分级为B级的患者可考虑TAE治疗,TAE对C级患者的治疗是否获益资料有限【Gbolahan O.B. 2017 Kishore S. 2017】。虽然TACE对B期疾病的推荐为1A级【Shah RP, 2011】,但由于与TACE相比的总费用高,特别是比较二者疗效的研究相互矛盾,一些机构依赖于TAE 或 "bland - embolization" 【Llovet JM, 2002 Malagari K, 2010 Brown KT, 2016 Marelli L, 2007】。年龄尚未被证明是影响TAE预后的因素【Thornton RH, 2009】。 对于包括TAE在内的所有局部区域治疗,患者的选择包括对患者的临床和血清学评估,包括功能状态、肝功能检查和临床指标,如ALBI(白蛋白-胆红素)、CP (Child-Pugh)、MELD(终末期肝病模型)和ECOG(东部肿瘤协作组)体力状态评分,用于患者分层和评估【Johnson P.J.2015 Levy I.2002 Guerrini G.P. 2018】。除诊断HCC外,术前影像学检查对于评估血管解剖结构、入路部位通畅性和确保门静脉通畅性至关重要【Sieghart W.2015】。研究表明,巴塞罗那临床肝癌分期分类系统(Barcelona Clinic Liver Cancer staging classification system, BCLC) B类患者从该手术中获益最大,其次是BCLC C类患者【Gbolahan O.B. 2017 Kishore S. 2017】。 根据米兰和UCSF标准,BCLC A级患者可以接受TAE以维持移植资格【Kishore S. 2017 Hodavance M.S.,2016】。图1显示了根据BCLC分类分层的可能治疗策略。
TAE 禁忌症:重要的是,TAE治疗没有明确的排除标准; 包括失代偿性肝硬化(Child-Pugh B8或更高)。但晚期肝硬化、总胆红素>4 mg/dL升高、血肌酐>2 mg/dL、门静脉受累和肝性脑病被认为是相对禁忌证。 TAE的禁忌证、门静脉血流量明显减少、肌酐清除率< 30 mL/min、高肿瘤负荷、严重合并症、未经治疗的食管静脉曲张和肝功能标志物升高【Raoul J.-L. 2011】。 TAE 技术上考虑
动脉内治疗的核心原则是肝细胞肿瘤主要由肝动脉分支供血,而正常肝实质主要通过门静脉接受双重血流【Kis B.2017 Breedis C. 1954 Gbolahan O.B. 2017】。所以在获得动脉通路后,使用导管和微导管组合来选择供应肿瘤的肝动脉分支。从该部位开始注入栓塞剂,直到所选动脉出现血流淤滞。
经动脉栓塞(TAE)的目的是限制肝动脉血流流向肿瘤供血血管。术中需明确肿瘤的主要供血肝动脉分支,超选择肿瘤滋养动脉,以最大限度地提高治疗效果,避免栓塞邻近的肝动脉分支导致正常肝实质的缺血。 栓塞缺血诱导的细胞膜破裂和胀亡,从而导致缺血性细胞死亡【Brown K.T., 1998】。颗粒和液体材料均可作为栓塞剂【Vaidya S., 2008】。所使用栓塞剂 (最常见的是粒径为40 ~ 120 μm的微粒【Rand T. 2005】)针对肝肿瘤动脉供血。导管动脉栓塞治疗的一个重要考虑因素是肿瘤内动静脉分流,如果颗粒太小,可能会无意中导致肺动脉栓塞。 TAE也被称为“Bland”栓塞,因为粒子本身不具备化疗或放疗等附加功能。
根据疾病在肝脏内的分布,治疗方法可以不同,包括对多灶性疾病的叶动脉的治疗或对单灶性疾病【Gaba R.C., 2017】的选择性肝段动脉治疗。有些患者可能需要全身麻醉【Zheng N. 2016,Coldwell D.M. 1989 Makary M.S.,2016 】,但TAE通常在镇静下在住院或门诊患者中进行。
micro-bland TAE最常见的粒径是40-120μm,以确保栓塞微粒渗透到肿瘤的末梢血管
患者可能会出现栓塞后综合征,在需要较大区域栓塞的患者中通常更严重。这通常是自限性的,可能在栓塞后72小时内出现腹痛、恶心、呕吐、肠梗阻、疲劳和/或发热【Castells A, 1995】。因此,接受TAE和TACE治疗的患者通常在出院前 (通常是第二天早上) 住院过夜,以控制疼痛。术后影像学和实验室评估通常在治疗后4 ~ 6周完成,以评估疗效。如果在术后影像学检查中发现额外的血管或疾病进展,治疗可能需要多次治疗。
最常见的相关风险是栓塞后综合征(postembolization syndrome, PES),其严重程度和持续时间可能与健康组织缺血程度和潜在的肝功能相关【Wigmore S.J. 2003 Paye F. 1999】。其他风险包括肝功能失代偿、肾损伤、胆道损伤、感染(脓肿)和罕见的肺栓塞(由于肿瘤内未被发现的动静脉分流和/或小栓塞颗粒)【Chan A.O., 2002 Garwood E.R. 2013 Wu G.C., 2009 】。最后,非靶向栓塞肝外血管(如胆囊动脉至胆囊)是另一个风险【Shah R.P.,2011】。术中使用锥形束CT等新型技术,以确保肿瘤完全覆盖,同时避免非靶栓塞【Kluger M.D. 2014】。
围手术期管理
在手术之前,患者可能会根据情况被给予预防性抗生素,以覆盖革兰氏阴性肠道微生物。Watchmaker 等人评估了肝栓塞前预防感染的必要性,发现手术本身的无菌技术足以在Oddi括约肌完好的患者中安全地进行手术【Watchmaker J.M.2018】;然而,对于既往胆道或肠道干预导致括约肌功能改变的患者,术后感染的风险明显更高【Song S.-Y. 2001】。因此,抗生素治疗和肠道准备可能对这些患者有益。例如,Khan等人发现,对肝脓肿形成高危患者,经肝动脉治疗前3天、术后17天口服400 mg莫西沙星可有效预防该并发症【Khan W. 2011】。另一种方案是在手术前每天使用左氧氟沙星和甲硝唑2天,并在栓塞前一天的下午1点、2点和11点联合使用新霉素加红霉素的肠道方案后继续使用2周【Patel S.,2006】。其他术前考虑包括水合状态、止吐、抗组胺和类固醇。一些机构使用地塞米松和氢化可的松。
手术后,充足的水分、疼痛和恶心控制以及稳定的肝功能检查是出院的关键标准。PES是栓塞治疗最常见的并发症,表现为右上腹部疼痛、恶心、疲劳、发热、高转氨酶血症和高胆红素血症【Wigmore S.J. 2003 Paye F. 1999 Castells A. 1995】。它通常在手术后72小时内发生,但在大多数情况下是自限性的,并在7至10天内完全消退【Castells A. 1995】。关于术后抗生素的常规给药存在争议,在获得更可靠的数据之前,这应该取决于病例的不同【Brown D.B., 2006】。具体而言,有胆道异常、胆肠干预或Oddi括约肌功能障碍病史的患者应继续使用抗生素2周【Khan W. 2011】。应遵循适当的围手术期抗凝管理指南【Pudusseri A.2014 Patel I.J. 2012】。4-6周后进行随访影像学和实验室检查,此后每3-6个月进行一次随访,以评估治疗成功并监测疾病进展【Gbolahan O.B. 2017 Haste P. 2018】。CT或MRI可证实肿瘤坏死【Gaba R.C. Radiol. 2017】。
Locoregional Therapy Approaches for Hepatocellular Carcinoma: Recent Advances and Management Strategies 单纯肝动脉栓塞:结果和预后 动脉内治疗在原发性肝细胞癌(HCC))患者中发挥了良好的作用。临床研究显示,TAE与TACE比较非劣效性。关于化疗联合栓塞在治疗肝细胞癌(HCC)中的作用,目前尚无明确的结论。比较患者经动脉单纯栓塞治疗(TAE)和经动脉化疗栓塞治疗(TACE)的客观反应率、毒性和长期预后或许会得出结论。 一项回顾性地纳入了265例在两个中心接受第一次TACE或TAE治疗的HCC患者。在治疗前记录临床和生物学特征,并在第一次治疗后使用改良的实体肿瘤反应评估标准(mRECIST)标准评估放射学反应【Roth 2021】。治疗和整体之间的相关性,无进展和无移植生存进行调整后使用倾向评分匹配: 86例患者单纯栓塞治疗和179例患者接受,包括44例药物洗脱珠和135碘油的治疗,89.8%的患者是男性平均年龄为65岁。90.9%的儿童Pugh评分为a的患者和84%的患者出现肝硬化。 经调整后,两种治疗方法之间的AE发生率,包括肝功能衰竭,没有任何差异。TACE与完全客观反应率(优势比(OR)= 8.5 (95%可信区间(CI):2.8-25.4))的显著增加相关,但与总反应率(OR=2.2(95%CI=0.8-5.8))无关。在TACE和TAE之间的总生存期(p = 0.3905)、无进展生存期(p = 0.4478)和无移植生存期(p = 0.9020)之间没有差异。与TAE相比,TACE与更高的完全放射反应率相关,但对总体放射反应、无进展生存期和总生存期没有任何影响
目前,各种临床分期系统被用于预测HCC动脉内治疗后的总生存期、无进展生存期和不良事件。例如Okuda系统、肝脏癌症意大利计划(Cancer of the Liver Italian Program, CLIP)评分、香港肝癌(Hong Kong Liver Cancer, HKLC)分期系统和巴塞罗那临床肝癌(Barcelona Clinic Liver Cancer, BCLC)分类方案【Grieco A.2005 Yau T. 2014】以及中国肝癌分期方案。在特定的预后因素中,肿瘤负荷、肝储备、肝外扩散和体能状态与HCC的总生存率密切相关【Grieco A.2005 Tsochatzis E.A.2014 Llovet J.M., 1999 Ni J.-Y. 2018】。评估治疗反应的金标准是2010年修订的《实体瘤疗效评价标准》(mRECIST)【Kim M.N. 2015】。
与最佳支持治疗相比,TAE治疗带来了显著的生存获益【Gbolahan O.B. 2017 Llovet J.M. 2002】。Tsochatzis等【Tsochatzis E.A.2014】发表了对6项比较TAE和TACE的随机对照试验的荟萃分析结果,没有一项试验显示总生存率有显著差异【Tsochatzis E.A.2014 Meyer T 2013】。Lee等人【Lee E.W.2017】总结了三项研究的证据,显示3年生存率、不良事件或RECIST应答无显著差异【Lee E.W. 2017 Kluger M.D.2014 Massarweh N.N.2016 Brown K.T.2016】。有趣的是,Kluger等【Kluger M.D.2014】发现,与TACE患者相比,TAE患者在移植前需要再次治疗的可能性显著降低。最后,2009年一项比较药物洗脱珠经动脉化疗栓塞(DEB-TACE)和TAE的多中心RCT发现,DEB-TACE组的至疾病进展时间显著改善,但总生存期无变化【Malagari K. 2010】。
最新证据 Outcomes of Transarterial Embolisation (TAE) vs. Transarterial Chemoembolisation (TACE) for Hepatocellular Carcinoma: A Systematic Review and Meta-Analysis 由于栓塞治疗引起的诱发性缺血可能是肿瘤细胞死亡的主要因素,而TAE栓塞确实避免了化疗的费用及其不良毒性【Chuang V.P. 1981 Tsochatzis E.A. 2013】,因此应继续经过适当选择的患者提供TAE。
研究已经证明TACE相对于支持性治疗有生存获益。而TAE则没有这样的比较数据;一些研究表明TAE的生存反应较差【Llovet JM, 2002】。虽然荟萃分析数据表明TAE相对于TACE具有非劣效性【Marelli L, 2007】,但2009年的一项比较DEB-TACE和TAE的近期前瞻性试验表明,DEB-TACE组的疾病进展时间(TTP)较长,完全缓解的个体百分比较高【Malagari K, 2010】。最近发表的一项研究表明,在比较bland栓塞和DEB栓塞时,肿瘤缓解、无进展生存期(PFS)或总生存期(OS)无差异【Brown KT, 2016】。因此,TAE和TACE在治疗中期HCC方面可能是相对平等的,尚不太可能完成明确的研究。
主要原因是医疗机构和医生个人发起的研究缺少庞大的资金支持,而TAE是过时的不赚钱的产品,有庞大资金的厂家难以支持这样的研究。这项研究的主要受益者是医疗赔付机构,也缺少动力进行这样的研究。未来恐怕需要国家基金,慈善基金?最可能的结局是新技术导致栓塞治疗成为历史。 单纯肝动脉栓塞适应症之一:肝细胞肝癌 ![]()
以下为TAE其它适应症单纯肝动脉栓塞适应症之二:神经内分泌肿瘤(NETs) 主要适合患者 - G1/G2 NET(GEP-NET,胃肠胰内分泌瘤) - Ki-67 < 10% - Liver dominant 什么时候可以考虑NETs的栓塞治疗 - 减轻症状(类癌综合征) - 降低肿瘤负荷(Debulking) SSA治疗后,局部治疗应该尽可能早的应用以防止功能性活性内分泌肿瘤的类癌危象(特别是中肠内分泌肿瘤典型的类癌综合征)。如果病变仅限于肝脏,局部治疗可以作为非功能肿瘤全身治疗的一个选项。 ![]()
![]() Hepatic neuroendocrine metastases: chemo- or bland embolization? Hepatic arterial embolization and chemoembolization for the treatment of patients with metastatic neuroendocrine tumors
Maire F.a · Lombard-Bohas C.d · O’Toole D.a · Vullierme M.-P.b · Rebo
![]() ![]() ![]() ![]() 此图片的顺序待整理(查原文) ![]() ![]() ![]() ![]() Histologically-Proven Efficacy of Bland Embolization in a Patient with Net Liver Metastasis TAE 适应症之三:GIST
- Sunitinib (second line)
![]() ![]()
Hepatic artery embolization for liver metastasis of gastrointestinal stromal tumor following imatinib and sunitinib therapy.
Bland embolisation: GIST
结论
Not be blind, Try to be bland!
Ki-67是在细胞G1,S,G2和M期出现的核抗原,由于其半衰期短,可以准确反映细胞的增殖活性,已广发应用与多种肿瘤的增殖活性测定。但其表达易受炎症和激素变化的而影响,如月经周期的黄体期和妊娠期,鳞状上皮基底上层细胞ki-67表达增加。
免疫组化简介 免疫组化,是应用免疫学基本原理——抗原抗体反应,即抗原与抗体特异性结合的原理,通过化学反应使标记抗体的显色剂(荧光素、酶、金属离子、同位素)显色来确定组织细胞内抗原(多肽和蛋白质),对其进行定位、定性及定量的研究,称为免疫组织化学技术(immunohistochemistry) 或免疫细胞化学技术 (immunocytochemistry) 免疫组化染色方法 将组织切片脱蜡,梯度酒精入水,在柠檬酸盐抗原修复液中修复,PBS缓冲液清洗,加入1:50稀释的ki-67蛋白抗体室温下孵育1h,标记辣根过氧化物酶的抗鼠二抗,室温下孵育45min,DBA显色,Mayer苏木精复染
染色结果判定
以棕褐色颗粒位于细胞核内判定为阳性染色结果,并根据Beesley分级法,按照阳性细胞数的比例将染色结果分为四级
同时计算阳性率的方法设定为:1.阳性率:指一级和一级以上的阳性染色病例百分数,2.强阳性率:指2级以及2级以上的阳性染色病例百分数
在不同癌细胞中阳性表达结果
SSA治疗简介 生长抑素类似物治疗的基础。
Pasireotide是一种新型的生长抑素类似物,目前正在研发中,其作用靶点为 SSTR1、2、3和56
背景:反应和生存
对TACE的反应:整体生存率独立预测因素
| |||||||||||||||||||||||||||||||||||||||||||||||||||||||||||||||||||||||||||||||||||||||||||||||||||||||||||||||||||||||||||||||||||||||||||||||||||
![]() |
发现病变动脉增强(定量)
精确发现另外没有发现的肿瘤供血
CBCT 发现肿瘤的敏感性 90% vs DSA 67%
CBCT 发现肿瘤供血动脉的敏感性 93% vs DSA 55%
![]() |
![]() |
与传统的DSA相比,选择性cTACE联合CBCT和AFD软件可改善无法手术的HCC患者的肿瘤反应,延长OS。
背景:CBCT和反应预期
![]() |
![]() |
| 肝动脉栓塞的靶点 |
到肝结节的动脉血流总是存在的,有时直接与肿瘤血管交通。更为常见的是,主要是肝转移癌,肿瘤血管直接与肝窦连接。
![]() |
|
“Such embolization of tumors can be obtained only with the use of calibrated TGMS of adapted caliber
to avoid proximal occlusion”
|
| 这种肿瘤的栓塞只能使用经校准的适配口径的TGMS,以避免近端闭塞。需要超选择栓塞 |